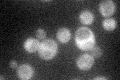
YDR515W
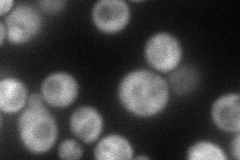
YDR515W
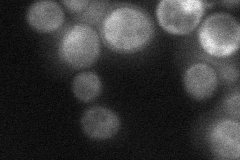
YDR515W
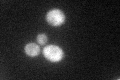
YDR515W
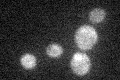
YDR515W

View description
RNA binding protein that associates with polysomes; proposed to be involved in regulating mRNA translation; involved in the copper-dependent mineralization of copper sulfide complexes on cell surface in cells cultured in copper salts
Localization:
Intensity:
Fold change:
Significance:
-
C’ GFP library in SD
cytosol39.59 -
N' NOP1pr-GFP in SD

cytosol51.8626 -
N' TEF2pr-mCherry in SD
cytosol70.2553 -
N' NATIVEpr-GFP in SD
cytosol39.3658 -
N' TEF2pr-VC and Cyto-VN in SD

#N/A0 -
C’ GFP library in SD+DTT
cytosol36.920.93No -
C’ GFP library in SD+H2O2

cytosol39.591No -
C’ GFP library in Starvation Media
cytosol22.60.57No -
C’ GFP library on the background of Pup2-DaMP

cytosol -
C’ GFP library on the background of CCT mutant

cytosol39.58240.999709No
